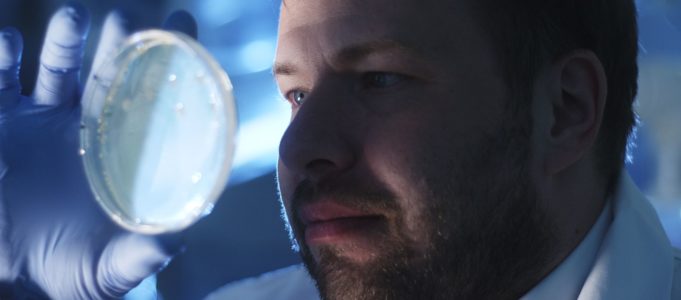

Frankfurt am Main/Berlin (pts016/04.08.2020/10:05) – * Neuer Lösungsansatz mit vermindertem Resistenzbildungsrisiko * Nutzen von Erkenntnissen aus der HIV-Forschung
Im Kampf gegen die weltweite Corona-Pandemie entwickelt das Berliner Forschungs- und Entwicklungsunternehmen ImmunoLogik ein Breitband-Virostatikum, das Patienten mit einer COVID-19-Erkrankung zu einer schnellen Genesung verhelfen soll. Die als IML-206 bezeichnete Substanz blockiert zelluläre Strukturen, die sehr wahrscheinlich für die Vermehrung des Virus unerlässlich sind. Die Erwartung der Wissenschaftler ist, dass die Ausbreitung des Virus im Körper zuverlässig gestoppt werden kann.
„Wir glauben, dass unser neuartiger Wirkstoffkandidat wesentlich effektiver wirkt und dazu besser verträglich ist als die bislang getesteten umgewidmeten Medikamente“, so Dr. Christian Setz, Geschäftsführer der Berliner ImmunoLogik GmbH. Da das Corona-Virus, wie alle Viren, mutiert, besteht bei vielen anderen, momentan getesteten Ansätzen, welche direkt Bausteine des Virus angreifen, die Gefahr, dass sich Medikamenten-Resistenzen bilden und die Therapie nach kurzer Zeit unwirksam wird. Diese Gefahr ist bei IML-206 sehr gering, da die Substanz nicht das Virus selbst, sondern genetisch stabile Bausteine der Wirtszellen, die weitaus weniger mutationsanfällig sind, beeinflusst.
Weiterhin ist diese Substanz sehr wahrscheinlich geeignet, um auch bei zukünftigen Ausbrü-chen von Coronaviren als zuverlässiges Breitband-Virostatikum zum Einsatz zu kommen, da die blockierten Bausteine der Zelle für eine ganze Bandbreite von Coronaviren unerlässlich sind. Anders als bei den zurzeit im Test befindlichen umgewidmeten Medikamenten, sind beim Einsatz von IML-206 zudem weniger Nebenwirkungen zu erwarten.
Hilfreiche Erkenntnisse aus der HIV-Forschung
Die Forscher von ImmunoLogik haben bereits sehr viel Know-how zu dieser Wirkstoffklasse aus ihrer jahrelangen Forschungsarbeit zur Bekämpfung des HI-Virus sammeln können. Hier ist das Ziel, mit einem Wirkstoff derselben Substanzklasse wie IML-206 den Ausbruch von AIDS bei austherapierten Patienten zu verhindern. Wie auch bei einer SARS-CoV-2-Infektion, gibt es bei HIV-Patienten das Risiko einer Resistenzbildung und von Unverträglichkeiten aufgrund von Nebenwirkungen der bislang eingesetzten Medikamente. Beide Entwicklungsprojekte laufen derzeit parallel und werden sich in den Studienergebnissen ergänzen. Erste Tests für IML-206 an menschlichen Probanden sollen 2022 beginnen.
Allein in den letzten zwei Jahrzehnten traten zwei aus dem Tierreich stammende Coronaviren – SARS und MERS – auf und verursachten teils lebensbedrohliche Erkrankungen. „Nach dem Ende des Ausbruchs von SARS endete damals unglücklicherweise auch die intensive Forschung an einem Wirkstoff gegen neu auftretende Coronaviren, sonst wären wir heute wahrscheinlich bereits besser gewappnet. Dieser Fehler sollte bei der aktuellen SARS-CoV-2-Pandemie nicht wieder passieren“, sagt Dr. Christian Setz. „Solche Coronavirus-Pandemien werden aller Voraussicht nach auch in Zukunft immer wieder auftreten. Daher ist die Entwicklung eines wirksamen Breitband-Virostatikums unerlässlich“, so Setz weiter.
Über ImmunoLogik Die ImmunoLogik GmbH mit Sitz in Berlin wurde 2012 gegründet mit dem Ziel, antivirale Wirk-stoffe zu entwickeln. Der Schwerpunkt der Forschung liegt auf der Entwicklung eines Wirkstoffes für die Behandlung von austherapierten HIV-Patienten, um den Ausbruch von AIDS zu verhindern. Im Februar 2020 wurde diese Forschungsarbeit in Zusammenarbeit mit einem Forscherteam der Friedrich-Alexander-Universität Erlangen-Nürnberg um den Fokus der Behandlung von COVID-19-Patienten erweitert. Zur Finanzierung der weiteren Forschungsarbeiten startet ImmunoLogik eine Kampagne auf der Crowdinvesting-Plattform Aescuvest http://www.aescuvest.de und ist damit Teil der Allianz # CrowdBeatsCorona. Strategischer Investor ist die Athenion Gruppe, die der ImmunoLogik im Verbund Zugriff auf interdisziplinäre Expertenteams aus Wirkstoffentwicklung, Projekt- und Qualitätsmanagement, Spezialisten im Bereich Business Development und Patentrecht ermöglicht. Weitere Informationen unter: http://www.aescuvest.de/projekte/immunologik2020
Für Presseanfragen: Christoph Lapczyna | PLÜCOM e.K. | T. 040 790 21 89 90 | E-Mail: cl@pluecom.de
Ansprechpartner Aescuvest GmbH: Frank Schwarz | T. 069 25474 1644 | E-Mail: press@aescuvest.eu
aescuvest ist die erste paneuropäische Crowdinvesting-Plattform, die sich auf den äußerst innovativen und nachhaltig wachsenden Gesundheitsmarkt spezialisiert hat. aescuvest eröffnet privaten wie institutionellen Anlegern die Möglichkeit, unternehmerische Investitionen in diesem chancenreichen Wirtschaftszweig mit überdurchschnittlichen Renditechancen zu tätigen. Unternehmen präsentieren auf der Plattform ihre smarten Ideen, patenten Produkte oder digitalen Konzepte, um sie mit Hilfe der Crowd zu finanzieren. Dabei erreichen sie ein Netzwerk von mehr als 550.000 Branchenexperten und platzieren ihre Idee direkt in der Zielgruppe und gegenüber einer breiten Öffentlichkeit. Mit Sitz im Finanzzentrum Frankfurt startete http://www.aescuvest.de als Crowdfunding-Plattform in Deutschland, um Innovationen aus den Bereichen Medizintechnik, Biotechnologie, Digitale Gesundheit, Gesundheitsimmobilie oder Dienstleistung verwirklichen zu können. 2018 markiert der Start von http://www.aescuvest.eu die Premiere einer Crowdfunding-Plattform für Unternehmen des Gesundheitssektors, die europaweit grenzüberschreitendes Finanzieren und Investieren möglich macht.
(Ende)
Aussender: Aescuvest GmbH Ansprechpartner: Frank Schwarz Tel.: +49 69 25474 1644 E-Mail: press@aescuvest.de Website: www.aescuvest.de